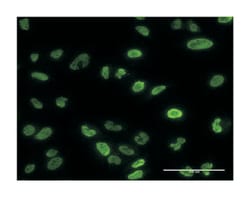
protein phosphatase 3 (formerly 2B), catalytic subunit, alpha isoform,

missing translation for 'onlineSavingsMsg'
Learn More
Learn More
protein phosphatase 3 (formerly 2B), catalytic subunit, alpha isoform, Mouse, Clone: 2G8, Abnova™
Mouse monoclonal antibody raised against a partial recombinant PPP3CA.
Brand: Abnova H00005530-M03.100ug
This item is not returnable.
View return policy
Description
Sequence: MSEPKAIDPKLSTTDRVVKAVPFPPSHRLTAKEVFDNDGKPRVDILKAHLMKEGRLEESVALRIITEGASILRQEKNLLDIDAPSpecifications
| protein phosphatase 3 (formerly 2B), catalytic subunit, alpha isoform | |
| Monoclonal | |
| Unconjugated | |
| PBS with no preservative; pH 7.4 | |
| NM_000944 | |
| PPP3CA | |
| PPP3CA (NP_000935, 1 a.a. ∼ 84 a.a) partial recombinant protein with GST tag. MW of the GST tag alone is 26 KDa. | |
| 100 μg | |
| Primary | |
| Human | |
| Antibody |
| ELISA, Immunofluorescence, Immunohistochemistry (PFA fixed), Western Blot | |
| 2G8 | |
| Mouse monoclonal antibody raised against a partial recombinant PPP3CA. | |
| PPP3CA | |
| CALN/CALNA/CALNA1/CCN1/CNA1/PPP2B | |
| Mouse | |
| Affinity Purified | |
| RUO | |
| 5530 | |
| Store at -20°C or lower. Aliquot to avoid repeated freezing and thawing. | |
| IgG2a κ |
Product Content Correction
Your input is important to us. Please complete this form to provide feedback related to the content on this product.
Product Title
Spot an opportunity for improvement?Share a Content Correction